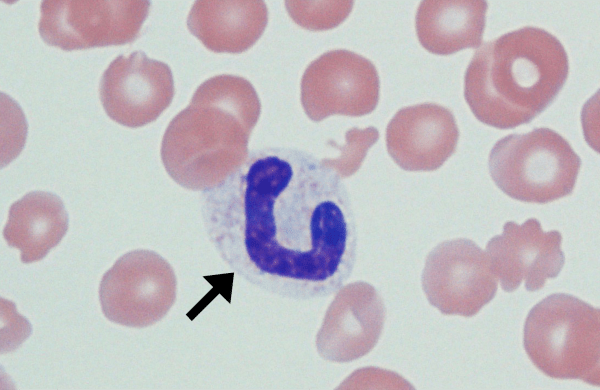

Bands (Left Shift)
Morphology: bands are immature neutrophils with an unsegmented horseshoe-shaped nucleus. Commonly seen with: toxic change Clinical relevance: left shift (↑ bands in peripheral blood) indicates inflammation. Left shift is more pronounced… Read more Bands (Left Shift) →
